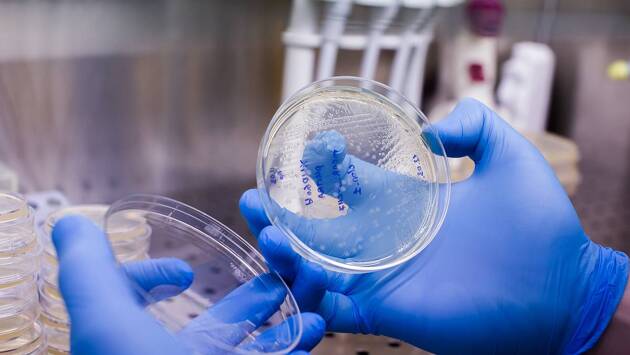

Генную терапию впервые применили для лечения ультраредкой болезни
Исследователи Госпиталя для больных детей в Торонто (SickKids) впервые применили индивидуальную генную терапию, чтобы вылечить ребенка от ультраредкого заболевания. Результаты исследования опубликованы в журнале Nature Medicine.
У мальчика была диагностирована спастическая параплегия типа 50 (SPG50) — прогрессирующее нейродегенеративное расстройство, которое вызывает задержки развития, нарушение речи, судороги, прогрессирующий паралич всех четырех конечностей, что значительно сокращает продолжительность жизни. Во всем мире известно около 80 детей с этим генетическим заболеванием.
Менее чем через три года после постановки диагноза пациенту была проведена первая в истории генная терапия, направленная на устранение дефекта, затрагивающего две копии гена AP4M1. Для этого в спинномозговую жидкость был введен вектор, несущий нормальную копию гена, что позволило доставить ДНК непосредственно в нервные клетки.
В течение 12 месяцев после лечения у ребенка не наблюдалось серьезных побочных эффектов, а SPG50 не прогрессировало. Более того, у пациента были зафиксированы некоторые признаки улучшения здоровья: мальчик мог опираться пятками на землю, а некоторые аспекты развития нервной системы вернулись в относительную норму.
Результаты исследования показывают, что можно быстро разработать и персонализировать генную терапию для пациентов с редкими генетическими заболеваниями, что дает надежду на применение этих методов для борьбы с другими расстройствами в будущем.